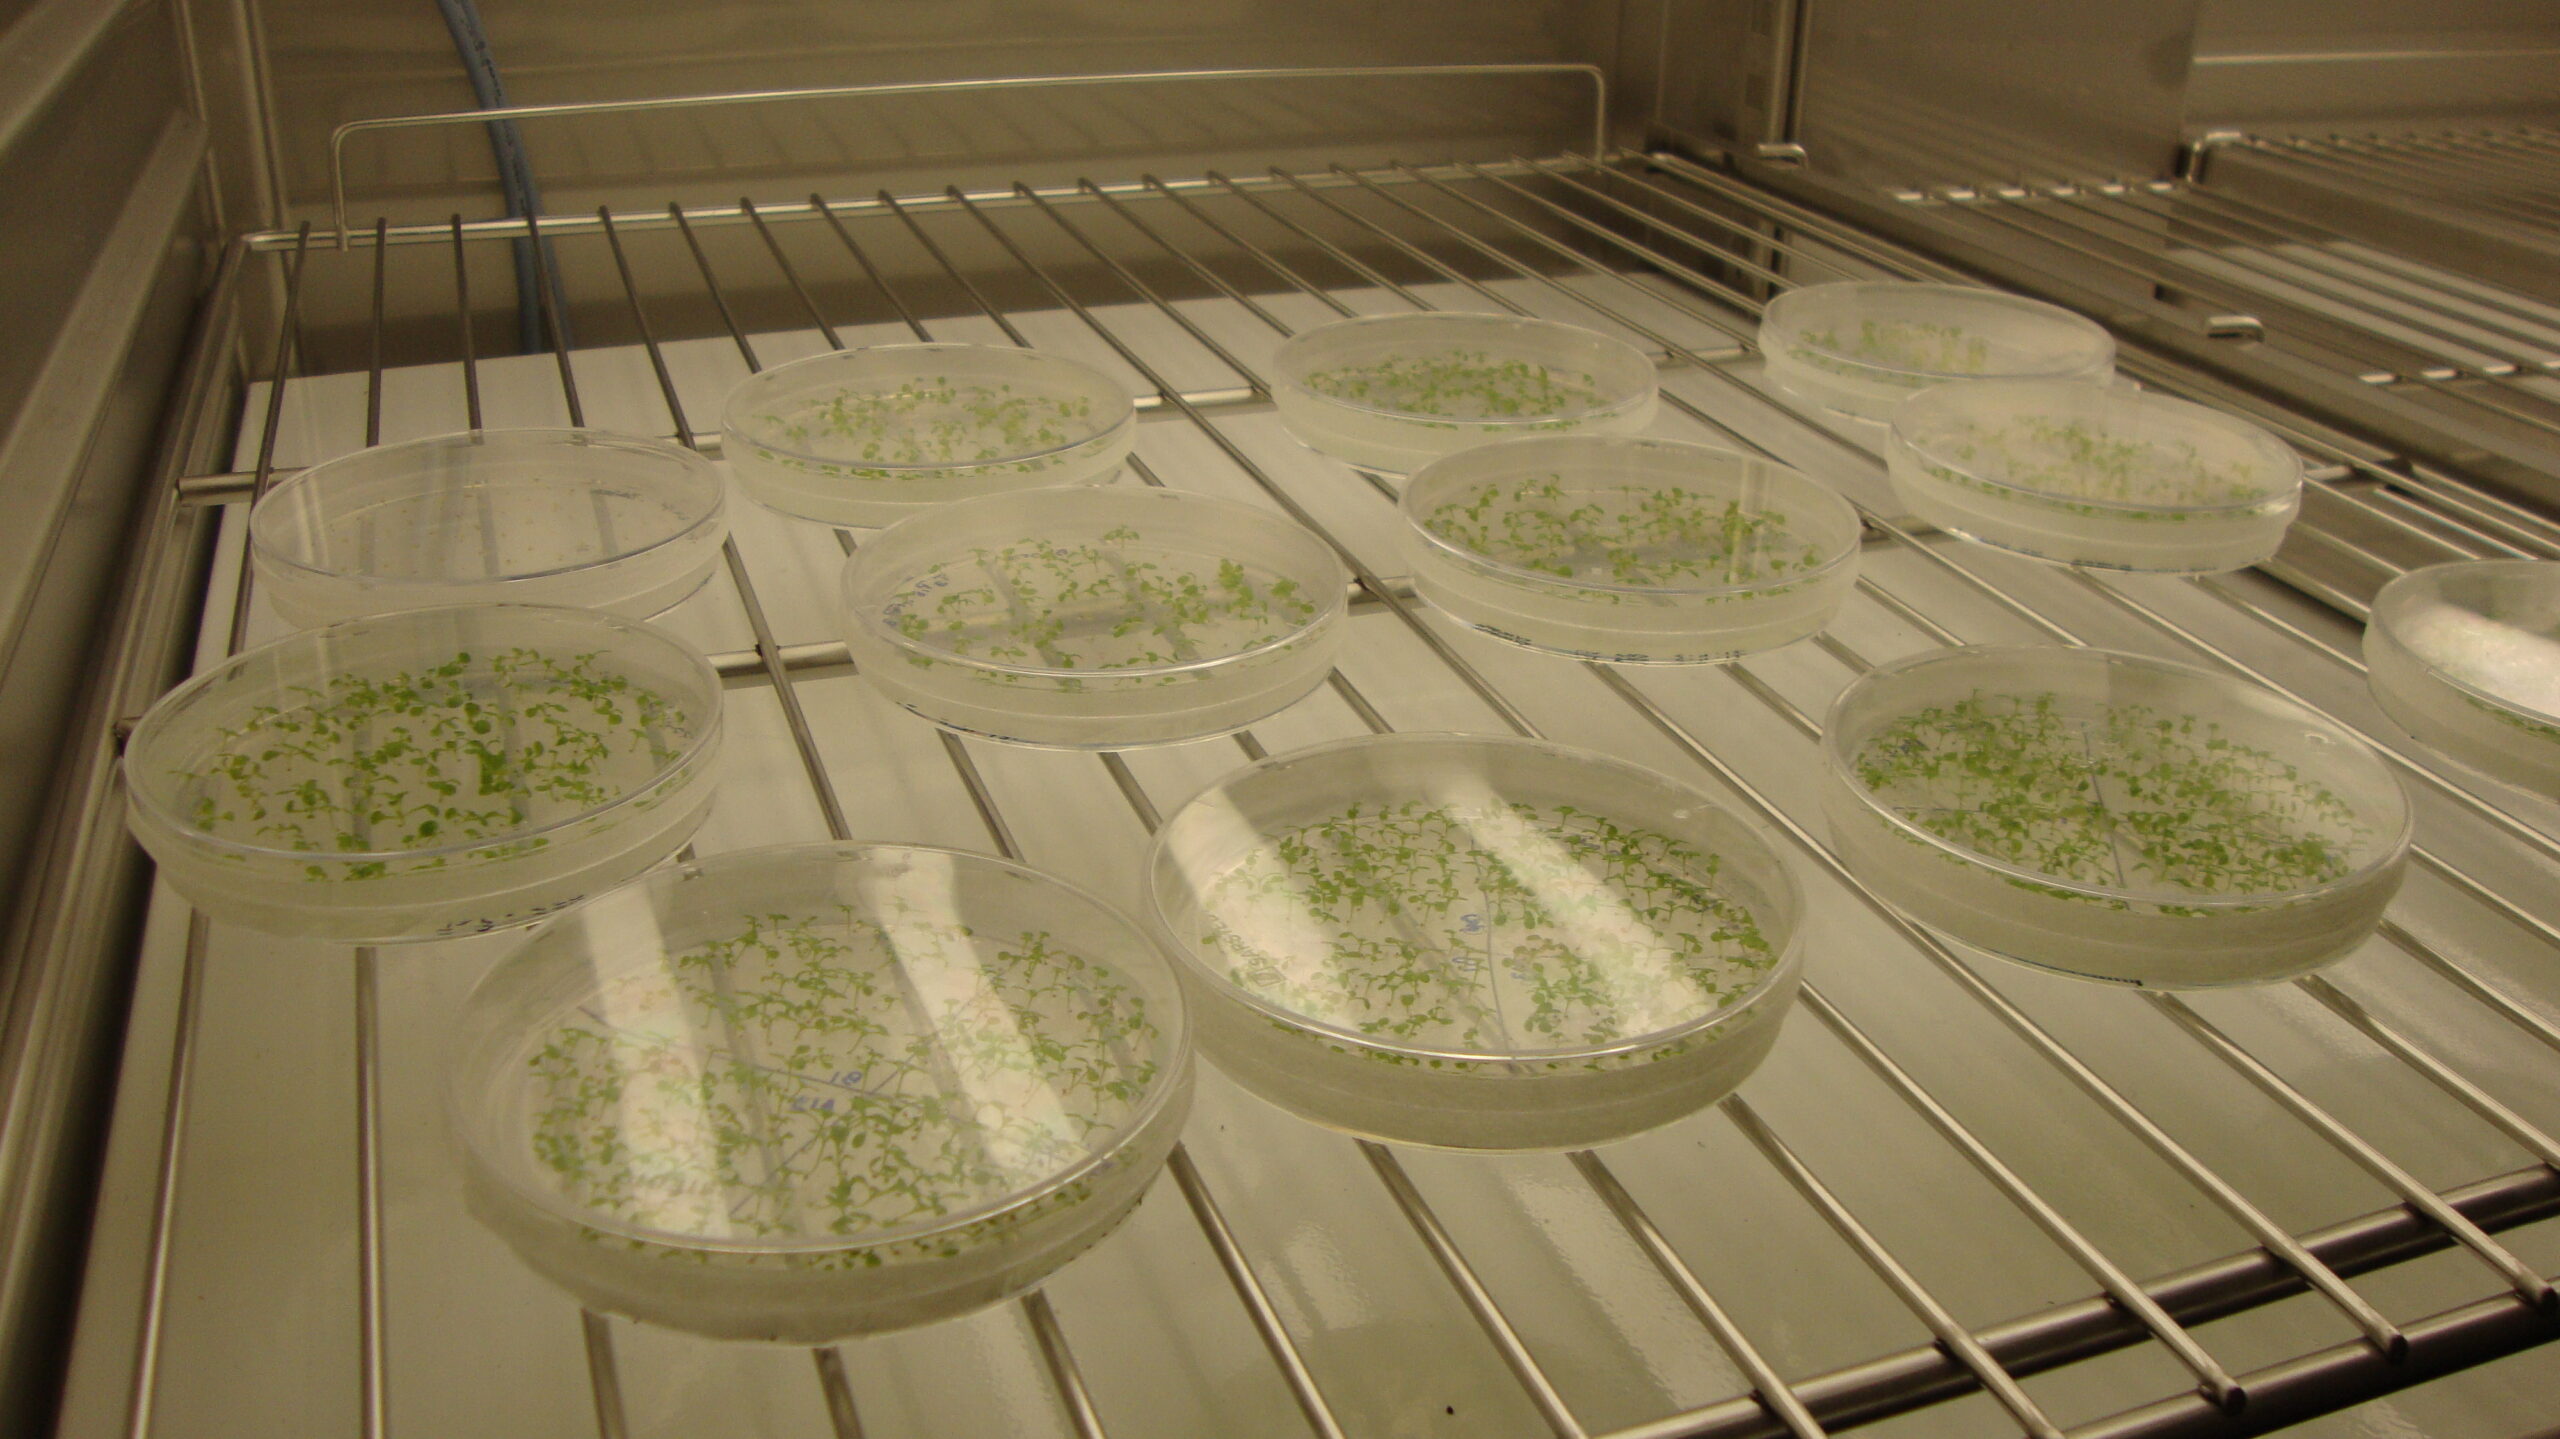

Reach-In Klimakammer FitoClima 600 Biotechnologie

Pflanzenwuchskammer speziell für die Forschung in den Bereichen:
- Pflanzenwachstum
- Gewebekultur
- Versuchspflanzen, Arabidopsis
- Keime
- Algen
- Insektenzucht, Entomologie
- Lagerung von Insekten
- Andere Life-Science-Anwendungen
Mit einer intelligenten Gesamtsteuerung ausgestattet, kann diese Kammer Einflussfaktoren wie Temperatur, Licht und Feuchtigkeit mit hoher Genauigkeit regulieren. Dies erlaubt eine präzise Simulation von klimatischen Umwelteinflüssen.
- Prüfraumvolumen: 600 Liter
- Temperaturbereich: 5 bis 45 °C
- Feuchtebereich: 40 bis 90 %RF
- Inklusive Multi-Color-Touch-Screen-Controller ClimaPlus
- Inklusive Racks mit Regalen und Tablaren